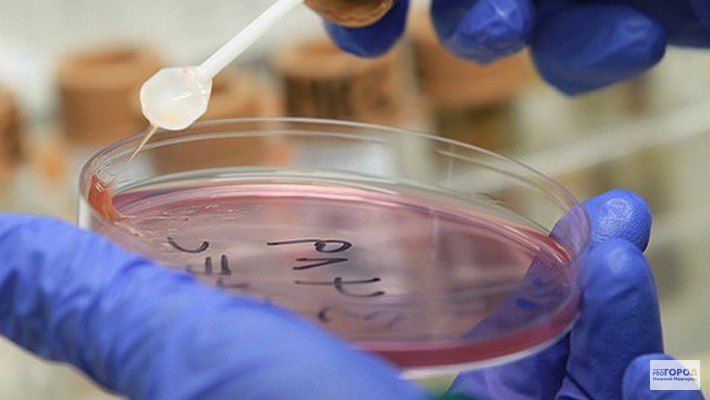
������������ �� �������� ��������� ������� ���������������

Новости за 04.09.2024
В Дубоссарах двое парней взломали хозпостройку и украли чужой мотоциклК краже молодые люди подготовились заранее. Совершали кражу ночью, завести не получилось, пришлось катить. Скрывая следы преступления, они отвезли мотоцикл в гараж одного из...
Минцифры ПМР объявляет о начале приёма заявок для участия в конкурсе «Человек года – 2024» С 5 сентября по 15 октября проводится отборочный этап ежегодного государственного конкурса «Человек года – 2024» Ведомственная экспертная комиссия при...
Серьезная авария у кишиневского аэропорта с участием 7 машин.
В Бендерах ко Дню города проведут регату на «драконах»К участию в соревнованиях допускаются любители физической культуры и спорта - сотрудники предприятий, ведомств, управлений, а также другие команды. По правилам — в лодке должно быть...
Президент Красносельский выразил соболезнования родным Марии Петровны:«Мария Петровна – настоящая защитница Отечества, обладавшая невероятной силой духа и мужеством. Как полевая связистка она обеспечивала бесперебойную связь, рискуя жизнью...
Не стало ветерана Великой Отечественной войны бендерчанки Марии Петровны Иосипчук. Ей был 101 год.На фронт Мария Петровна ушла в 1943 году, принимала участие в освобождении Молдавии. Была награждена орденом Отечественной войны I-й степени...
Не стало ветерана Великой Отечественной из Бендер Марии Иосипчук. В ноябре ей бы исполнилось 102 года.Мария Петровна добровольцем ушла на фронт в 1943 году. Была связисткой. Участвовала в Ясско-Кишинёвской операции. Дважды была ранена.У Марии Иосипчук...
Дыхание любви28 сентября в Бендерской крепости зазвучит золотой голос Италии Рикардо Маринелло. Оперный певец исполнит известные произведения в сопровождении приднестровского Государственного симфонического оркестра.В цитадели будут звучать арии...
Умерла ветеран Великой Отечественной войны Мария Петровна Иосипчук. Ей был 101 год.Соболезнование в связи с уходом из жизни Марии Петровны выразил Президент.«Мария Петровна – настоящая защитница Отечества, обладавшая невероятной силой духа и...
Республика гордится вами! В преддверии Дня Республики в Каменке состоялось торжественное собрание, на котором чествовали жителей района, внёсших вклад в развитие и укрепление Приднестровской Молдавской Республики.В зале районного Дома культуры...
Умерла ветеран Великой Отечественной войны Мария Петровна Иосипчук. Ей был 101 год.Мария Петровна была участником Ясско-Кишинёвской операции, участвовала в освобождении Молдавии. Была награждена орденом Отечественной войны I-й степени...
В связи с уходом из жизни Марии Петровны Иосипчук соболезнования родным и близким ветерана выразил Президент ПМР Вадим Красносельский:«Мария Петровна – настоящая защитница Отечества, обладавшая невероятной силой духа и мужеством. Её путь от родной...
Приднестровские кикбоксёры взяли 3 «золота» и «бронзу» на чемпионате в Будапеште среди кадет и юниоров:Даниил Максименко (Рыбница)Дмитрий Венгер (Рыбница)Кирилл Сапрыгин (Рыбница)Алексей Чилей (Тирасполь)В соревнованиях участвовали более 2...
Помогли животномуСтоличные спасатели 4 сентября поднялись по выдвижной лестнице, чтобы помочь кошке-инвалиду. У бедняги перебиты задние лапы. Она ходит с трудом, но, испугавшись собак, от страха взобралась на трёхметровую высоту. На дереве просидела...
Центризбирком Молдовы намерен сократить число участков для жителей Приднестровья сразу на десять — с 41, которые были открыты на прошлых, досрочных парламентских выборах, до 31 участка.В 2020-м году на президентских выборах в Молдове...
Кручу-верчу, машины выдаюПарковка-карусель в Китае. Автомобили поднимают на высоту 5-го этажа. По нажатию кнопки спускают обратно.
Эпидситуация по кишечным инфекциям остаётся неблагополучной.На прошлой неделе выявили 86 случаев заболевания. Это на 13,2% больше, чем на предыдущей неделе. Рост заболеваемости отмечен в Бендерах, Слободзейском и Дубоссарском районах.Анализ воды...
Уволиться — миссия невыполнима!В Японии увольнение рассматривается как неуважение, и подать заявление об уходе крайне сложно. Работники часто сталкиваются с давлением и даже угрозами от начальства. Некоторые обращаются в агентства по...
Перчатка на памятьСегодня в столице спасатели поднялись по выдвижной лестнице, чтобы помочь кошке-инвалиду. У бедняги перебиты задние лапы. Даже ходит с трудом. Но испугалась собак и от страха забралась на трёхметровую высоту. На...
На 102 году жизни не стало ветерана Великой Отечественной войны, участницы Ясско-Кишиневской операции, ветерана труда Марии Иосипчук На фронт ушла в 1943 году, была радисткой в зенитно-артиллерийском полку. Принимала участие в освобождении Молдавии....